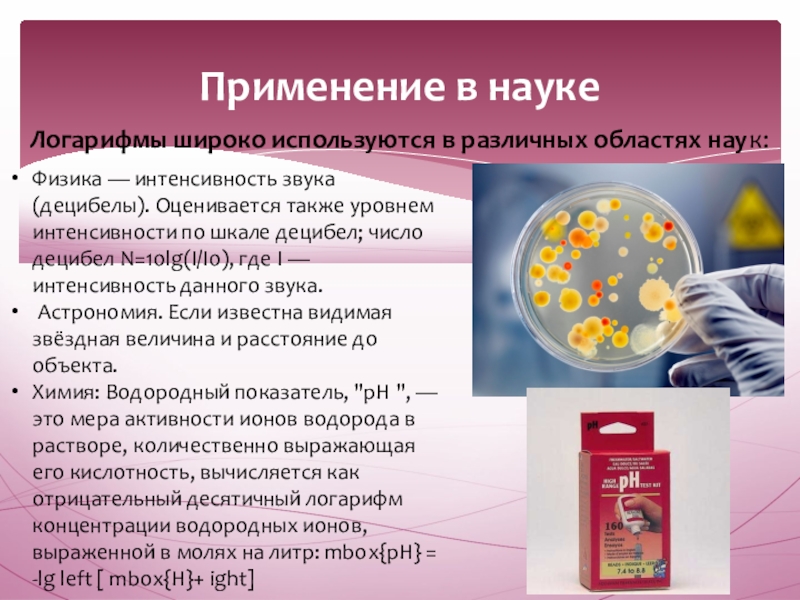

- Главная
- Разное
- Образование
- Спорт
- Естествознание
- Природоведение
- Религиоведение
- Французский язык
- Черчение
- Английский язык
- Астрономия
- Алгебра
- Биология
- География
- Геометрия
- Детские презентации
- Информатика
- История
- Литература
- Математика
- Музыка
- МХК
- Немецкий язык
- ОБЖ
- Обществознание
- Окружающий мир
- Педагогика
- Русский язык
- Технология
- Физика
- Философия
- Химия
- Шаблоны, фоны, картинки для презентаций
- Экология
- Экономика
Презентация, доклад по теме Применение логарифмической функции
Содержание
- 1. Презентация по теме Применение логарифмической функции
- 2. В 1614 году шотландский математик-любитель Джон Непер
- 3. Логарифмическая спиральСпирали – плоские кривые линии, многократно
- 4. Логарифмическая спиральПервым ученым, открывшим эту удивительную кривую,
- 5. Применение в природе. Особенности логарифмической спирали поражали не
- 6. Слайд 6
- 7. Применение в природе Один из наиболее распространенных
- 8. Применение в природеСпирали широко проявляют себя в
- 9. Слайд 9
- 10. Слайд 10
- 11. По логарифмическим спиралям закручены и многие галактики, в частности Галактика, которой принадлежит Солнечная система.
- 12. Логарифмические линии в природе замечают не только
- 13. Применение в наукеФизика — интенсивность звука (децибелы).
- 14. Применение в наукеВ сейсмологии: При вычислении магнитуды.
- 15. Логарифмы «на слуху» и в ухе Когда
- 16. «Без знания математики нельзя понять ни основ
- 17. Слайд 17
- 18. Рассмотренные нами примеры убедительно показывают, что знание
- 19. Используемая литератураhttp://medznate.ru/docs/index-19622.htmlhttp://www.slideshare.net/slavaantipov14/ss-43946309
- 20. Слайд 20
Слайд 1Применение логарифмической функции
Автор: ученица 11 а класса, МБОУСОШ №9,
г. Североморск
Яблокова
Руководитель:
Шкурко Елена Владимировна,
учитель математики
Слайд 2В 1614 году шотландский математик-любитель Джон Непер опубликовал на латинском языке
История возникновения логарифма
Слайд 3Логарифмическая спираль
Спирали – плоские кривые линии, многократно обходящие одну из точек
Логарифмическая спираль является траекторией точки, которая движется вдоль равномерно вращающейся прямой, удаляясь от полюса со скоростью, пропорциональной пройденному расстоянию.
Точнее, в логарифмической спирали угол поворота пропорционален логарифму этого расстояния.
Слайд 4Логарифмическая спираль
Первым ученым, открывшим эту удивительную кривую, был Рене Декарт (1596-1650г.г.).
Логарифмическая спираль часто используется в технических устройствах. Например, вращающиеся ножи имеют профиль, очерченный по логарифмической спирали- под постоянным углом к разрезаемой поверхности, благодаря чему лезвие ножа стачивается равномерно.
Ночные бабочки, которые пролетают большие расстояние, ориентируясь по параллельным лунным лучам, инстинктивно сохраняют постоянный угол между направлением полета и лучом света. Если же они ориентируются на точечный источник света, скажем, на пламя свечи, то инстинкт их подводит, и бабочки попадают в пламя по скручивающейся логарифмической спирали.
Слайд 5Применение в природе
. Особенности логарифмической спирали поражали не только математиков. Ее свойства
Слайд 7Применение в природе
Один из наиболее распространенных пауков, эпейра, сплетая паутину,
Хищные птицы кружат над добычей по логарифмической спирали. Дело в том, что они лучше видят, если смотрят не прямо на добычу, а чуть в сторону.
Слайд 8Применение в природе
Спирали широко проявляют себя в живой природе. Спирально закручиваются
Рога таких рогатых млекопитающих, как архары – горные козлы, закручены по логарифмической спирали.
В подсолнухе семечки расположены по дугам, близким к логарифмической спирали.
Слайд 11По логарифмическим спиралям закручены и многие галактики, в частности Галактика, которой
Слайд 12Логарифмические линии в природе замечают не только математики, но и художники,
Слайд 13Применение в науке
Физика — интенсивность звука (децибелы). Оценивается также уровнем интенсивности
Астрономия. Если известна видимая звёздная величина и расстояние до объекта.
Химия: Водородный показатель, "pH ", — это мера активности ионов водорода в растворе, количественно выражающая его кислотность, вычисляется как отрицательный десятичный логарифм концентрации водородных ионов, выраженной в молях на литр: mbox{pH} = -lg left [ mbox{H}+ ight]
Логарифмы широко используются в различных областях наук:
Слайд 14Применение в науке
В сейсмологии: При вычислении магнитуды. Магнитуда землетрясения — величина,
ЛОГАРИФМИЧЕСКАЯ ШКАЛА Примеры применения:
Шкала Рихтера интенсивности землетрясений
Шкала экспозиций в фотографии
Звездные величины — шкала яркости звезд
Шкала рН
Шкала интенсивности звука — децибелы
Шкала частоты звука — нотная шкала
Слайд 15Логарифмы «на слуху» и в ухе
Когда мы слышим игру музыкальных инструментов
В основе устройства музыкальной гаммы лежат определенные закономерности. Для построения гаммы гораздо удобнее пользоваться, оказывается, логарифмами соответствующих частот: log 2w0, log 2w1... log 2wm
1 — наружный слуховой проход; 2 — барабанная перепонка; 3 — полость среднего уха (барабанная полость); 4 — молоточек; 5 — наковальня; 6 — стремечко; 7 — полукружные каналы; 8 — преддверие; 9 — улитка; 10 — овальное окно; 11 — евстахиева труба.
Рассматривая устройство уха, можно заметить орган, который называется улиткой. Контур «улитки» можно соотнести с логарифмической спиралью в математике.
Слайд 16«Без знания математики нельзя понять ни основ современной техники, ни того,
ученые изучают природные и социальные явления»
Колмогоров. А.Н
Логарифмы в географии и архитектуре